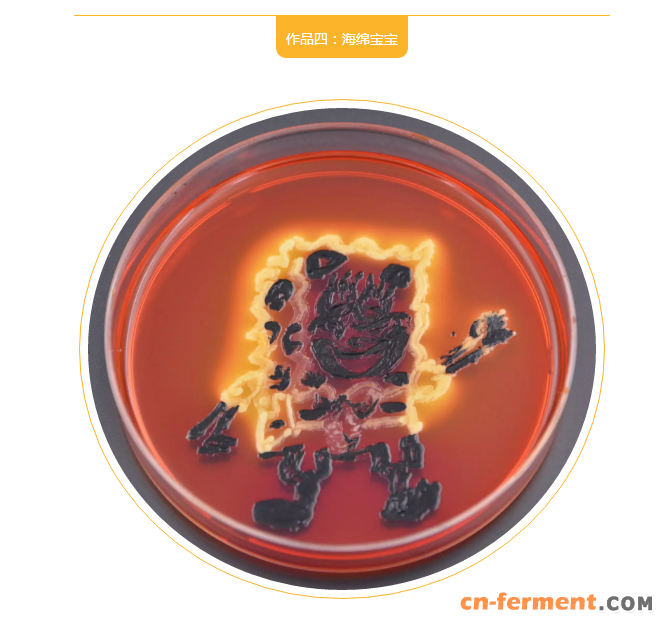
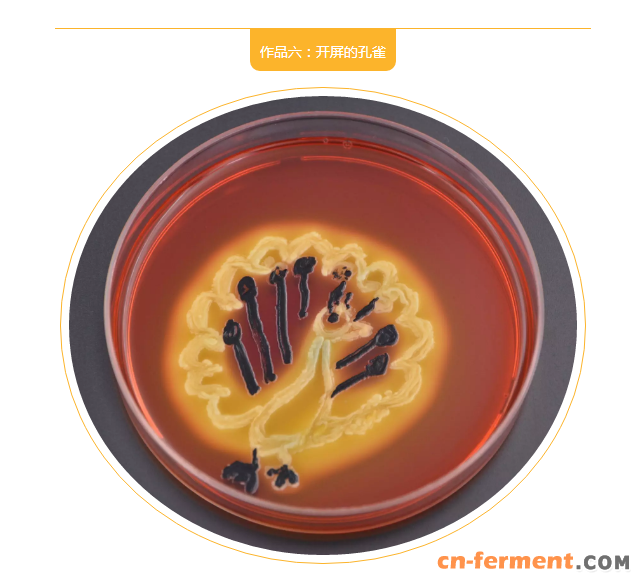
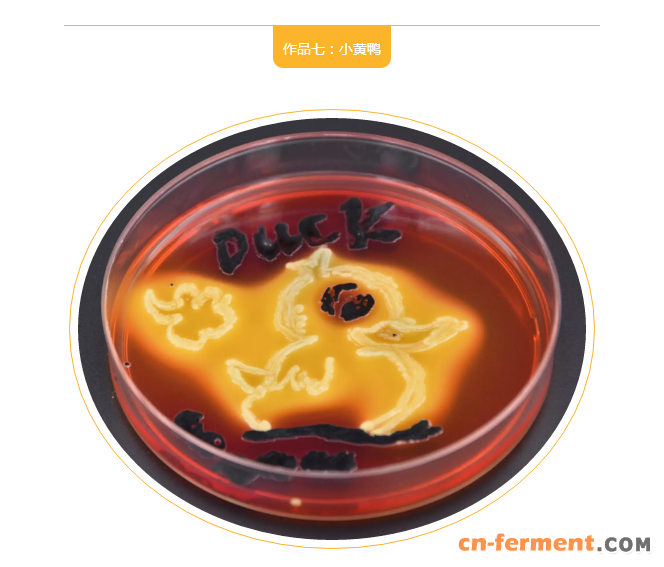

身边CNAS实验室的美眉们看到朋友圈里的培养皿绘画大赛,按捺不住尝试新鲜事物的好奇心,决定让培养物按照自己的意愿长出来。
她们把平日工作的剩余平板和工作菌株当作颜料和画板,开始释放自己的创作欲望。

米奇是80后最爱的卡通形象

向日葵的花语是“沉默的爱,没有说出口的爱”,向日葵绽放的是梦想和对生活的热爱

充满童趣的螃蟹和海星,一定是天真的你画的吧!
一看就知道这是绘画高手,把海绵宝宝憨态可掬的表情描绘的惟妙惟肖
![]()


平皿的规格限制了长颈鹿的身高,但是这小小的长颈鹿还是那么可爱
这开屏的孔雀自带光环哦!
![]()

这长长的鸭嘴让我们想起调皮可爱的唐老鸭

这是梦想照进现实的花朵嘛!花笑的合不拢嘴,给大家带来了快乐
以上这些作品的培养基是木糖赖氨酸脱氧胆盐培养基,黄色的是大肠埃希氏菌杆菌,黑色的是鼠伤寒沙门氏菌。






